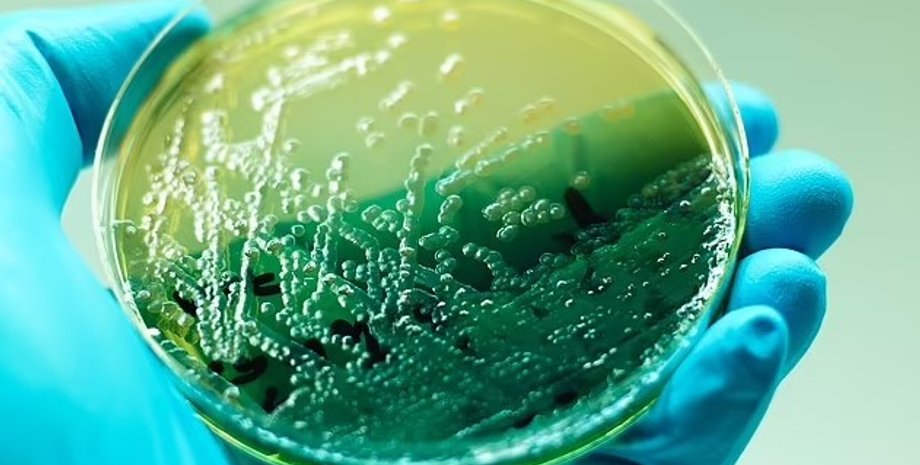
бактерии, бактерии на носках

Грязнее половика. Ученые рассказали, что общего у наших носков и тараканов с фекалиями
Неприятная правда об одной из части нашего гардероба заставит нас не носить носки больше одного дня, и уж точно не ложиться в них в постель.
Ученые согласны с тем, что ношение носков перед сном может быть залогом хорошего сна, поскольку помогает регулировать температуру тела. Однако настаивают, что нам не следует лезть в постель в той паре, которую вы носили в течение дня и для этого есть веские аргументы, пишет Daily Mail.
Новое исследование показывает, что носки после целого дня использования, грязнее чем пульт от телевизора и даже полового коврика. Новое исследование было проведено под руководством доктора Деборы Ли, специалистом в области здравоохранения и медицинским писателем в Dr Fox Online Pharmacy.
У Фокус. Технологии появился свой Telegram-канал. Подписывайтесь, чтобы не пропускать самые свежие и захватывающие новости из мира науки!
Исследователи провели ряд экспериментов и обнаружили на носках бактерии E.coli и Pseudomonas aeruginosa — патогены, которые, как правило, обнаруживаются на тараканах и в фекалиях. Именно поэтому исследователи полагают, что нам следует надевать перед сном новую пару, если мы привыкли спать в носках.
Дело в том, что наши ноги имеют около 250 тысяч потовых желез. Если мы носим носки с самого утра и до следующего дня, в них может накапливаться влага, в результате чего будут размножаться бактерии и другие микроорганизмы.
По словам доктора Ли, ночью наша постель теплая, а мы потеем, что делает ее идеальной средой для размножения патогенов, таких как:
- псевдомонада;
- золотистый стафилококк;
- кишечная палочка.
Перед стартом испытаний, ученые провели опрос, в котором приняли участие чуть более тысячи человек. 18% из них заявили, что спят в носках, однако лишь около трети, сказали, что меняют носки перед тем как лечь в постель.
Далее ученые провели ряд экспериментов, где изучили 8 мужских и женских носков, которые носили с 7 утра и до 11 вечера. Каждый реципиент носил одни и те же носки, когда носил обувь, тренировался или занимался повседневными делами. Исследователи также взяли образцы с пульта для телевизора и коврика, а затем сравнили их с носками.
По словам доктора Ли, на четырех образцах они с коллегами обнаружили следы синегнойной палочки (Pseudomonas aeruginosa), которая также встречается на тараканах и в фекалиях. Отметим, что, как правило, эти бактерии редко поражают здоровых людей, однако у людей с ослабленным иммунитетом они могут вызвать:
- поражение дыхательных путей;
- поражение мочевыводящих путей.
Результаты исследования также свидетельствуют о том, что синегнойная палочка также была обнаружена на коврике, однако ее не было на пульте. На носках также были обнаружены следы Clostridium perfringens — патогенной бактерии, которая является одной из самых распространенных причин пищевых отравлений, а также Bacillus cereus, вызывающую рвоту и диарею.
Кроме того, в образцах были замечены кишечные палочки, а также золотистый стафилококк, который является частой причиной кожных и респираторных инфекций, а также пищевых отравлений.
Исследователи предупреждают, что ложась в постель в таких носках, вы переносите весь этот рассадник бактерий в нее. А потому следует надевать чистые носки каждый раз, перед тем как идти спать. Более того, носки, нижнее и постельное белье рекомендуют стирать при температуре не ниже 50 градусов, чтобы очистить их от бактерий и вирусов.
Ранее Фокус писал о том, что ученые рассказали, как часто нужно стирать постельное белье.

